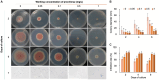
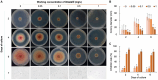
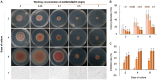

Identification of the Ilex macrocarpa anthracnose pathogen and the antifungal potential of the cell-free supernatant of Bacillus velezensis against Colletotrichum fioriniae
- PMID: 38966396
- PMCID: PMC11222323
- DOI: 10.3389/fmicb.2024.1419436
Identification of the Ilex macrocarpa anthracnose pathogen and the antifungal potential of the cell-free supernatant of Bacillus velezensis against Colletotrichum fioriniae
Abstract
Introduction: Anthracnose is a significant fungal disease that affects tree growth and development, with Colletotrichum spp. exhibiting host non-specificity and targeting various organs, making disease control challenging.
Methods: This study aimed to identify the pathogenic species causing anthracnose in Ilex macrocarpa in Nanchong, Sichuan Province, and screen effective fungicides, particularly biological ones. The pathogen was identified as Colletotrichum fioriniae through morphological observation, pathogenicity assays, and molecular biological methods. Three biological and five chemical fungicides were evaluated for their effects on the mycelial growth and spore germination rate of the pathogen.
Results: The results indicated that prochloraz was the most effective chemical fungicide, while the cell-free supernatant (CFS) of Bacillus velezensis had the most significant inhibitory effect among the biological fungicides. Transcriptome analysis revealed that the CFS of B. velezensis significantly reduced the expression of genes associated with ribosomes, genetic information processing, membrane lipid metabolism, and sphingolipid biosynthesis in C. fioriniae. Additionally, the glutathione pathway's expression of various genes, including key genes such as GST, GFA, Grx, TRR, and POD, was induced. Furthermore, the expression of 17 MFS transporters and 9 ABC transporters was increased. Autophagy-related ATGs were also affected by the B. velezensis CFS.
Discussion: These findings suggest that the B. velezensis CFS may inhibit C. fioriniae through interference with ribosomes, genetic information processing, cell membrane metabolism, and energy metabolism. These results provide potential target genes for the B. velezensis CFS and insights into the antifungal mechanism by which B. velezensis inhibits C. fioriniae.
Keywords: Bacillus velezensis; Colletotrichum fioriniae; Ilex macrocarpa; anthracnose; biocontrol.
Copyright © 2024 Fu, Wan, Yang, Zhao, Yan, Jiang and Ali.
Conflict of interest statement
The authors declare that the research was conducted in the absence of any commercial or financial relationships that could be construed as a potential conflict of interest.
Figures

References
-
- Ahmed W., Zhou G., Yang J., Munir S., Ahmed A., Liu Q., et al. . (2022). Bacillus amyloliquefaciens WS-10 as a potential plant growth-promoter and biocontrol agent for bacterial wilt disease of flue-cured tobacco. Egypt J. Biol. Pest Control 32:25. doi: 10.1186/s41938-022-00527-5 - DOI
-
- Bordoh P. K., Ali A., Dickinson M., Siddiqui Y., Romanazzi G. (2020). A review on the management of postharvest anthracnose in dragon fruits caused by Colletotrichum spp. Crop Prot. 130:105067. doi: 10.1016/j.cropro.2019.105067 - DOI
-
- Broberg M., Simaan H., Shmoish M., Rabner A., Karlsson M., Horwitz B. A. (2021). Ferulic acid, an abundant maize phenolic, regulates ABC and MFS transporter gene expression in the maize pathogen Cochliobolus heterostrophus. J. Plant Dis. Prot. 128, 1383–1391. doi: 10.1007/s41348-021-00451-0 - DOI
LinkOut - more resources
Full Text Sources
Research Materials
Miscellaneous